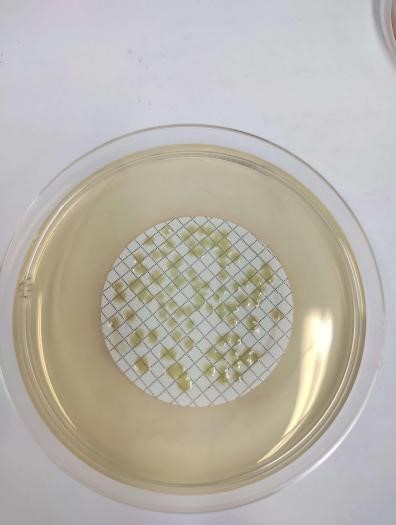
a

5935次
2025-04-1621世紀是生物科學蓬勃發展的年代,各類生物制品成為許多生物科技公司一大重點研發領域,包括重組蛋白與抗體產品、mRNA產品、基因治療產品、CAR-T產品、疫苗產品等等,無不例外涉及到細胞建庫的問題。
細胞庫建立與充分的檢定對后續藥物研發以及商業生產環節都至關重要,能確保生產的可持續性及產品的一致性,細胞庫被污染將直接影響產品的安全性,同時給企業帶來巨大的損失。
中國、美國、歐洲等藥典明確規定必須對細胞庫進行充分檢定后才可用于生產,同時也是CDE和FDA審查的必審項目,需高度重視。
華微檢測結合中外法規和實際案例,對生物制品的細胞庫檢定內容歸納解讀為三部分:微生物檢查篇、內外源病毒檢查篇、特異性病毒檢查篇。
本篇將詳細介紹微生物檢查部分。
微生物檢查又包括細菌、真菌檢查、分枝桿菌檢查以及支原體檢查,其中細菌、真菌檢查、分枝桿菌檢查屬于無菌檢查,其主要的檢測依據為《中國藥典》2020年版 三部通則 1101無菌檢查法。無菌檢查法系用于檢查藥典要求無菌的藥品、生物制品、醫療器械、原料、輔料及其他品種是否無菌的一種方法。
值得注意的是,若供試品符合無菌檢查法的規定,僅表明了供試品在該檢驗條件下未發生微生物污染。
目前USP、EP的無菌檢查法已通過ICH完成協調一致,《中國藥典》2020年版的無菌檢查法與他國藥典的各項主要參數基本也一致,主要差異點見表1:
表1 不同藥典里無菌檢查法的差異分析

華微檢測可參照《中國藥典》(2020版)三部通則1101無菌檢查法在B+A環境中進行無菌檢查,可提供薄膜過濾法和直接接種法,如下圖1:
銅綠假單胞菌

金黃色葡萄球菌

黑曲霉

陰性對照
圖1 無菌檢查圖示
2020年版《中國藥典》指出主細胞庫、工作細胞庫、病毒種子批、對照細胞以及臨床治療用細胞進行支原體檢查時,應同時進行培養法和指示細胞培養法(DNA染色法)。病毒類疫苗的病毒收獲液、原液采用培養法檢査支原體,必要時,亦可采用指示細胞培養法篩選培養基。也可采用經國家藥品檢定機構認可的其他方法。
培養法作為支原體檢測的金標準,在中國藥典、美國藥典和歐洲藥典中都是作為基本的檢測方法而使用,其之間的主要差異點如表2~3:
表2 不同藥典里對支原體檢查中培養法的要求

表3 不同藥典里對支原體檢查中指示細胞培養法的要求

華微檢測可參照《中國藥典》(2020版)三部通則3301支原體檢查法的要求進行,可提供符合法規要求的支原體檢查,包括培養法和指示細胞培養法,培養法檢測的靈敏度高于中國藥典要求,肺炎支原體達到10-9,口腔支原體達到10-5,如下圖2~5:

圖2 肺炎支原體培養基靈敏度檢查(從左到右分別10-7、10-8、10-9(各3管),陰性對照)

圖3 口腔支原體培養基靈敏度檢查(從左到右分別10-3、10-4、10-5(各3管),陰性對照)

圖4 熒光顯微鏡下的肺炎支原體

圖5 熒光顯微鏡下的口腔支原體
華微檢測細胞庫檢定服務
華微檢測實驗室配備有多間加強型生物安全二級實驗室(P2),已在廣州市備案,實驗室按照GMP質量體系運行,且通過CMA、CNAS評審,B+A環境,滿足無菌及相關病毒檢測的環境要求。
遵循FDA、CHP、EP、ICH等多個國內外法規和指導原則進行設計,建立了全面的細胞庫檢定操作規程,主要包括以下幾個方面:細胞鑒別、無菌檢查、支原體檢查、內外源病毒因子檢查、成瘤性/致瘤性檢查、染色體檢查等。
檢測項目及方法見下表4:
掃碼添加史工 掃碼添加嚴工

掃碼添加史工 掃碼添加嚴工
聯系人:史工18928790749、嚴工
聯系電話:19924323595、020-82118202、020-31608627
地址:廣州市黃埔區攬月路3號F棟316(總部)廣州市黃埔區科學城尖塔山路1號(動物中心)



